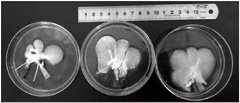

CN109671346B - Liver model and preparation method and application thereof - Google Patents
Liver model and preparation method and application thereofDownload PDFInfo
- Publication number
- CN109671346B CN109671346BCN201910042221.8ACN201910042221ACN109671346BCN 109671346 BCN109671346 BCN 109671346BCN 201910042221 ACN201910042221 ACN 201910042221ACN 109671346 BCN109671346 BCN 109671346B
- Authority
- CN
- China
- Prior art keywords
- liver
- agent
- cleaning agent
- cleaning
- decellularized
- Prior art date
- Legal status (The legal status is an assumption and is not a legal conclusion. Google has not performed a legal analysis and makes no representation as to the accuracy of the status listed.)
- Active
Links
Images
Classifications
- G—PHYSICS
- G09—EDUCATION; CRYPTOGRAPHY; DISPLAY; ADVERTISING; SEALS
- G09B—EDUCATIONAL OR DEMONSTRATION APPLIANCES; APPLIANCES FOR TEACHING, OR COMMUNICATING WITH, THE BLIND, DEAF OR MUTE; MODELS; PLANETARIA; GLOBES; MAPS; DIAGRAMS
- G09B23/00—Models for scientific, medical, or mathematical purposes, e.g. full-sized devices for demonstration purposes
- G09B23/28—Models for scientific, medical, or mathematical purposes, e.g. full-sized devices for demonstration purposes for medicine
- G—PHYSICS
- G09—EDUCATION; CRYPTOGRAPHY; DISPLAY; ADVERTISING; SEALS
- G09B—EDUCATIONAL OR DEMONSTRATION APPLIANCES; APPLIANCES FOR TEACHING, OR COMMUNICATING WITH, THE BLIND, DEAF OR MUTE; MODELS; PLANETARIA; GLOBES; MAPS; DIAGRAMS
- G09B23/00—Models for scientific, medical, or mathematical purposes, e.g. full-sized devices for demonstration purposes
- G09B23/28—Models for scientific, medical, or mathematical purposes, e.g. full-sized devices for demonstration purposes for medicine
- G09B23/30—Anatomical models
- G09B23/306—Anatomical models comprising real biological tissue
Landscapes
- Engineering & Computer Science (AREA)
- Physics & Mathematics (AREA)
- General Physics & Mathematics (AREA)
- Health & Medical Sciences (AREA)
- General Health & Medical Sciences (AREA)
- Mathematical Analysis (AREA)
- Business, Economics & Management (AREA)
- Algebra (AREA)
- Computational Mathematics (AREA)
- Medical Informatics (AREA)
- Chemical & Material Sciences (AREA)
- Mathematical Optimization (AREA)
- Mathematical Physics (AREA)
- Pure & Applied Mathematics (AREA)
- Medicinal Chemistry (AREA)
- Educational Administration (AREA)
- Educational Technology (AREA)
- Theoretical Computer Science (AREA)
- Life Sciences & Earth Sciences (AREA)
- Biomedical Technology (AREA)
- Molecular Biology (AREA)
- Medicines Containing Material From Animals Or Micro-Organisms (AREA)
- Investigating Or Analysing Biological Materials (AREA)
Abstract
Description
Technical Field
The invention relates to the field of tissue engineering, in particular to a liver model and a preparation method and application thereof.
Background
Transcatheter hepatic artery Chemoembolization (TACE) is one of the most commonly used interventional procedures for the treatment of hepatocellular carcinoma. The embolization agent used in transcatheter hepatic artery chemoembolization is a commonly used conventional medical device, such as iodized oil, gelatin sponge particles, and polyvinyl alcohol microspheres. The agent embolization effect of embolizing agents is currently commonly studied using two models:
(1) the model simulates multilevel blood vessel distribution of the liver based on a microfluidic chip, and injects the embolic agent into the model to observe and evaluate the embolic effect. For example, two or more microfluidic chips are connected in parallel to form a microvascular simulation zone, and the system pressure is monitored after the embolic agent is injected to evaluate the embolic strength of the embolic agent.
(2) Animal model in vivo, animal with tumor or normal animal in liver is used as model in vivo, and it is subjected to transcatheter vascular embolization to inject embolization agent into target blood vessel in vivo. Common animals include rabbits, rats, and pigs. For example, in vivo in a new zealand rabbit which is normal or carries VX2 tumor, the embolizing agent is delivered to a target blood vessel for embolization through transcatheter vascular embolization, the small animal is observed for about two weeks after the embolization, and the embolization effect after the embolization is evaluated by combining the technologies of magnetic resonance imaging, electronic computer tomography, digital subtraction angiography and the like.
The existing assessment means of the effect of the embolic agent has certain limitations. Firstly, for the in vitro microfluidic model, the microfluidic chip is used for simulating blood vessels of all levels of the liver and the actual blood vessel system of the liver, and the material of the microfluidic chip is usually polydimethylsiloxane and other artificial polymer materials, which have certain difference with the mechanical property of the actual blood vessel. Secondly, if animals are used to evaluate the embolization effect of embolization agents, significant money and time are spent in performing embolization operations and in animal care after operations, and the process requires a large number of expensive supporting facilities and involvement of multiple professionals. In addition, the results of in vivo experiments are not intuitive, and expensive instruments such as a nuclear magnetic resonance imager, a digital subtraction angiography instrument and the like are needed for observing and evaluating the embolism effect, or the liver is taken out after a long time (such as two weeks) after the operation to observe and evaluate the embolism effect. In addition, most of the existing microparticle or microsphere embolic agents do not have developing capability, and contrast agents are required to be additionally injected for developing observation in the operation and postoperative evaluation, so that the operation difficulty and cost are increased.
Disclosure of Invention
Based on this, it is necessary to provide a liver model with a high degree of visualization.
In addition, a preparation method and application of the liver model with high visualization degree are also provided.
A method for preparing a liver model comprises the following steps:
decellularizing the liver to obtain a decellularized liver; and
reinforcing the decellularized liver with a cross-linking agent to obtain the liver model.
Compared with an in-vitro microfluidic model, the blood vessel system arrangement and the mechanical property of the liver model prepared by the preparation method of the liver model are closer to the pathological liver of a real hepatocellular carcinoma patient, particularly the internal blood supply system of a tumor can be reserved, and the tumor blood vessel system can not be simulated by the current microfluidic model.
Compared with the method for researching the embolism effect by using animals, the method for preparing the liver model has the advantages of low preparation cost, short preparation time, capability of saving a large amount of time and cost and considerable economic value. In addition, the liver model prepared by the preparation method of the liver model completely reserves the three-dimensional structure of the blood vessel system in the liver, is transparent as a whole, has clear and visible internal blood vessels, can directly observe the embolization process, the distribution of the embolization agent and the embolization effect without expensive equipment such as a digital subtraction angiography instrument and the like, and can be suitable for the embolization agent without developing capability. Furthermore, the liver source used in the preparation method of the liver model is not limited, and the liver can be dead liver of mice, rats, rabbits, pigs, monkeys, dogs, sheep and the like or human, and abundant animal species can provide more choices for research of the embolic agent. The liver model prepared by the preparation method of the liver model is not easy to rot and collapse after decellularization, and can be stored for a long time under a freezing condition. Compared with the method of directly using animals, the method is easy to carry and store, and has no risk of infection diseases and the like.
A liver model is prepared by the preparation method of the liver model.
The application of the liver model in detecting the effect of the embolic agent.
Drawings
FIG. 1 is the fresh liver of example 6;
FIG. 2 is liver of example 6 after 24h freezing;
FIG. 3 shows the liver of example 6 after washing with purified water;
FIG. 4 shows the liver of example 6 after TritonX-100 treatment;
FIG. 5 is the liver of example 6 after treatment with 0.5% SDS;
FIG. 6 is a liver model of example 1;
FIG. 7 is a liver model of examples 4 and 5;
FIG. 8 is a graph showing the result of staining a section of decellularized liver according to example 6;
FIG. 9 is an electron microscope image of the decellularized liver of example 6;
FIG. 10 is a stereomicroscope image of the decellularized liver of example 6;
FIG. 11 is a graph comparing the DNA content in the decellularized liver of example 6 with a blank control;
FIG. 12 is a graph showing the embolization effect of the liver model of example 6;
FIG. 13 is a graph showing the effect of injecting iodized oil into the liver model of example 6;
FIG. 14 is a view showing the operation of injecting an embolizing agent directly into the inside of a blood vessel of the liver model of example 6 using a long needle for embolization.
Detailed Description
To facilitate an understanding of the invention, the invention will now be described more fully with reference to the accompanying drawings. Some embodiments of the invention are presented in the drawings. This invention may, however, be embodied in many different forms and should not be construed as limited to the embodiments set forth herein. Rather, these embodiments are provided so that this disclosure will be thorough and complete.
Unless defined otherwise, all technical and scientific terms used herein have the same meaning as commonly understood by one of ordinary skill in the art to which this invention belongs. The terminology used in the description of the invention herein is for the purpose of describing particular embodiments only and is not intended to be limiting of the invention.
The method for preparing a liver model according to an embodiment includes the steps of:
s110, freezing the isolated liver.
The liver used in the present embodiment refers to an isolated liver. The isolated liver can be liver with lesion or injury of mouse, rat, rabbit, pig, monkey, dog and sheep. Such as tumor-bearing liver, further such as new zealand rabbit liver bearing VX2 tumor, or cadaveric liver of liver cancer patient obtained according to corresponding national laws and ethical principles, etc. The isolated liver can also be the healthy liver of mice, rats, rabbits, pigs, monkeys, dogs, sheep and other animals. In the present embodiment, the liver used means the whole liver. Of course, it will be appreciated that in other embodiments, a portion of the liver may be used according to actual needs.
Specifically, the freezing temperature is-70 ℃ to-80 ℃, and the time is more than 6 hours. Further, the freezing temperature was-80 ℃ and the freezing time was 8 hours or 12 hours.
Freezing the liver facilitates the destruction of cells in the liver, facilitating decellularisation. Of course, in other embodiments, decellularization may also be assisted by sonication, High Intensity Focused Ultrasound (HIFU), or the like, as long as the cells of the liver tissue can be destroyed without affecting the extracellular matrix. It will be appreciated that in some embodiments, step S110 may be omitted, in which case the subsequent steps are performed directly with unfrozen liver.
S130, decellularizing the liver to obtain the decellularized liver.
Specifically, the liver after freezing is thawed and then decellularized to obtain a decellularized liver. Methods of decellularization include physical methods, chemical methods, and enzymatic methods. Among them, chemical methods and enzymatic methods may be used in combination in the method of decellularization, and of course, they may be used alone.
In one embodiment, the liver is washed with a wash agent comprising at least one of an ionic surfactant, a non-ionic surfactant, and an amphoteric surfactant.
Specifically, the cleaning agent comprises at least one of Triton X-100, Triton X-200, sodium dodecyl sulfate, sodium deoxycholate, polyethylene glycol, EDTA, EGTA, CHAPS (3- [3- (cholamidopropyl) dimethylamino ] propanesulfonate inner salt), sulfobetaine-10 (sulfobetaine-10), sulfobetaine-16 (sulfobetaine-16), alkylphenol ethoxylates (APEO), high-carbon fatty alcohol polyoxyethylene ether (AEO), fatty acid polyoxyethylene ester (AE), fatty acid methyl ester ethoxylate (FMEE), polyether nonionic surfactant, polyoxyethylated ionic surfactant, polyhydric alcohol type surfactant and sulfonate type anionic surfactant.
Further, the alkylphenol ethoxylates include at least one of octylphenol polyoxyethylene ether and nonylphenol polyoxyethylene ether. The polyether type nonionic surfactant includes ethylene oxide adducts of polypropylene glycol. The sulfonate type anionic surfactant includes at least one of sodium alkyl sulfonate, sodium alkylaryl sulfonate, sodium alkyl sulfate and secondary sodium alkyl sulfate. Polyoxyethylenated ionic surfactants include Alcohol Ether Sulfates (AES). The polyol-type surfactant includes sorbitan esters.
Specifically, the cleaning agent comprises a first cleaning agent and a second cleaning agent. Further, the first cleaning agent is selected from one of TritonX-100 and polyethylene glycol. The second cleaning agent is selected from one of Sodium Dodecyl Sulfate (SDS), sodium deoxycholate and TritonX-200. Further, the first cleaning agent is 0.1-10% of TritonX-100. Further, the first cleaning agent is 1% TritonX-100, 2% TritonX-100 or 4% TritonX-100. The second cleaning agent is 0.1-10% of sodium dodecyl sulfate, and further, the second cleaning agent is 0.1% of sodium dodecyl sulfate, 0.5% of sodium dodecyl sulfate or 1% of sodium dodecyl sulfate. Proved by verification, the liver is cleaned according to the proportion of the first cleaning agent and the second cleaning agent, the time for preparing the liver model can be greatly shortened, and the preparation efficiency is improved.
Specifically, the cleaning time of the first cleaning agent is 0.1 to 100 hours. Further, the cleaning time of the first cleaning agent is 1 to 12 hours. Further, the cleaning time of the first cleaning agent is 1 hour, 2 hours, or 4 hours. The cleaning time of the second cleaning agent is 0.1-100 hours. Further, the cleaning time of the second cleaning agent is 1 to 10 hours. Further, the cleaning time of the second cleaning agent is 3 hours, 4 hours or 6 hours.
Specifically, the flow rate of the first cleaning agent is 0.1mL/min to 100 mL/min. Further, the flow rate of the first cleaning agent is 5mL/min to 12 mL/min. Further, the flow rate of the first purge is 6mL/min, 7mL/min, or 10 mL/min. The flow rate of the second cleaning agent is 0.1mL/min to 100 mL/min. Further, the flow rate of the second cleaning agent is 5mL/min to 10 mL/min. Still further, the flow rate of the second purge is 6mL/min, 7mL/min, or 10 mL/min. In one embodiment, the flow rate of the first rinsing agent is the same as the flow rate of the second rinsing agent.
Further, the liver is washed with a first wash and then with a second wash to obtain a decellularized liver.
In one embodiment, the method further comprises the step of rinsing the liver with water prior to rinsing the liver with the rinsing agent. This step enables the removal of red blood cells and the lysis of cells in the liver. Specifically, the water is washed for 10min to 30min by pure water.
In another embodiment, the liver is treated with a protease to decellularize the liver. Wherein the enzyme is at least one selected from trypsin, endonuclease and exonuclease.
In one embodiment, the liver is flushed with a wash agent; and treating the liver with a protease.
It will be appreciated that the liver may also be decellularised in other ways commonly used in the art.
S150, reinforcing the decellularized liver by using a cross-linking agent to obtain a liver model.
Specifically, the cross-linking agent is added into the decellularized liver at the flow rate of 0.1mL/min to 100mL/min, and the liver model is obtained after 0.1h to 10 h. Further, the flow rate of the added cross-linking agent is 5mL/min, 7mL/min or 10mL/min, and the time for introducing the cross-linking agent is 2h, 1.5h or 1 h. The cross-linking agent can effectively improve the mechanical stability of the decellularized liver and prevent the internal structure of the liver from collapsing. The cross-linking agent also prevents the deformation and shrinkage of volatile water caused by the movement of macromolecules and the penetration of water molecules, and is more beneficial to storage and repeated use.
Specifically, the crosslinking agent includes imide ester crosslinking agents, N-hydroxysuccinimide ester crosslinking agents (e.g., NHS ester, N-hydroxysuccinimide (NHS)), maleimide crosslinking agents, haloacetyl crosslinking agents (e.g., SIA, SIAB and SIAB sulfide), dithiodipyridine crosslinking agents (e.g., LC-SPDP sulfide and PDPH), hydrazide crosslinking agents, carbodiimide crosslinking agents (e.g., EDC [ 1-ethyl-3- (3-dimethylaminopropyl) -carbodiimide ], organic peroxide crosslinking agents, silane crosslinking agents, azide crosslinking agents, divinyl sulfone crosslinking agents, 1, 4-butanediol diglycidyl ether crosslinking agents, crosslinking agents containing two or more unsaturated bonds, amines, oximes, organic sulfides, phenols, phenol crosslinking agents, and the like, At least one of organic dibasic acid, polyalcohol, glutaraldehyde, formaldehyde, acetic anhydride, diglycidyl ether, methyl suberate, carbodiimide, sodium alginate oxide, gelatin, chitosan, aziridine, amino resin, genipin and N-hydroxysuccinimide. Further, the organosulfide includes a crosslinking agent containing two or more mercapto groups. It should be noted that "two or more" herein includes two.
In one embodiment, the crosslinking agent comprises N-hydroxysuccinimide and 1-ethyl- (3-dimethylaminopropyl) -3-ethylcarbodiimide hydrochloride. Further, the cross-linking agent is a mixture of N-hydroxysuccinimide and 1-ethyl- (3-dimethylaminopropyl) -3-ethylcarbodiimide hydrochloride, wherein the molar concentration ratio of the N-hydroxysuccinimide to the 1-ethyl- (3-dimethylaminopropyl) -3-ethylcarbodiimide hydrochloride is 1: 1-10. Further, the molar concentration ratio of N-hydroxysuccinimide to 1-ethyl- (3-dimethylaminopropyl) -3-ethylcarbodiimide hydrochloride is 1:1 to 10. Further, the molar concentration ratio of N-hydroxysuccinimide to 1-ethyl- (3-dimethylaminopropyl) -3-ethylcarbodiimide hydrochloride is 1:4, 1:6 or 1: 8.
In one embodiment, the standing time is 0.1 to 24 hours. Further, the mixture was left standing for 1 hour, 2 hours or 4 hours.
In one embodiment, the cross-linking agent is added to the decellularized liver at a flow rate of 1mL/min to 20 mL/min. Further, the flow rate of the cross-linking agent added to the decellularized liver is 4mL/min to 15 mL/min. Further, the cross-linking agent is added to the decellularized liver at a flow rate of 5mL/min, 7mL/min, or 10 mL/min.
The preparation method of the liver model is simple and convenient to operate and can be used for large-scale production.
A liver model is prepared by the preparation method of the liver model.
The liver model has at least the following advantages:
(1) the transparent and visual degree is high, the distribution of the embolic agent in the model and the embolization effect can be visually observed without the assistance of instruments such as a digital subtraction angiography instrument, and the like, and the method is particularly suitable for the embolic agent without developing capability.
(2) The product is not easy to collapse and has long storage time, and can be stored for 7 days in a cold storage mode, and can be stored for more than 30 days in a freezing storage mode at the temperature of minus 20 ℃ to minus 80 ℃. The shape of the decellularized liver can be maintained by adding the fixing liquid for the scanning electron microscope, and the storage time can be prolonged and can be stored for more than three months.
(3) Can be applied to the liver with tumor, and can truly reproduce the three-dimensional structure of the internal vascular system of the tumor liver in vitro.
(4) Compared with animals, the animal feed is easy to carry and store, and has no risk of infection diseases and the like.
(5) The preparation cost is low, the time required by the preparation is short, a large amount of time and cost can be saved, and the method has considerable economic value.
The application of the liver model in detecting the effect of the embolic agent.
A method of detecting the effect of an embolic agent comprising the steps of:
adding an embolic agent to the liver model; and detecting the embolization effect of the embolizing agent.
Specifically, the step of adding an embolic agent to the liver model comprises the following operations: mixing the medicine and the embolic agent to obtain a mixture; and introducing the mixture into the tumor site for embolization.
The effect evaluation method of the embolic agent can evaluate various performances of the embolic agent so as to achieve the purpose of screening or researching and developing the embolic agent. The above-described method for evaluating the effect of an embolic agent has, but is not limited to, the following properties:
(1) the distribution of the embolic agent in the hepatic vasculature and the depth of delivery were evaluated. Because the acellular liver in-vitro model is transparent, the distribution and the delivery depth of the embolic agent in the liver vascular system, particularly the condition of internal blood vessels and external supply arteries of a tumor, can be observed by using a microscope after the embolization, and the delivery performance of the embolic agent and whether the embolization is mistakenly performed in the embolization can be evaluated. As can be seen, the iodooil is densely deposited in the tumor internal vessels of this model.
(2) The morphology of embolic agents in vascular systems at various levels. By using the above cell removal model, the true shape of the embolic agent in the blood vessel can be observed, such as the deformation of the elastic polyvinyl alcohol microspheres caused by the extrusion of the blood vessel wall and the phenomenon of the flow interruption of the iodized oil in the blood vessel, and the cell removal model can be used for researching the mechanical properties of the embolic agent.
(3) The embolizing ability of the embolizing agent was evaluated. After embolization saline, pure water or other solutions were perfused from the hepatic artery or portal vein into the decellularized liver using a peristaltic pump to see if the embolization agent would be washed out in the model.
(4) The particle size range of the embolization particles or microspheres is screened. Based on the observed distribution of the embolic agent in the liver model and the depth of delivery, the delivery capacity of embolic agents of different particle sizes can be evaluated.
DETAILED DESCRIPTION OF EMBODIMENT (S) OF INVENTION
The following detailed description is given with reference to specific examples. The examples, which are not specifically illustrated, employ drugs and equipment, all of which are conventional in the art. The experimental procedures, in which specific conditions are not indicated in the examples, were carried out according to conventional conditions, such as those described in the literature, in books, or as recommended by the manufacturer.
Examples 1 to 5
(1) As shown in table 1, livers of examples 1 to 6 and blank controls (untreated livers) were provided, wherein the livers of examples 1 to 6 and blank controls were obtained from the experimental animal center of guangzhou province, and the biological sizes of the livers of examples 1 to 6 and blank controls were the same. The fresh liver of example 6 is shown in fig. 1. Livers of each example and blank (untreated livers) were frozen for 24 h. In example 6, the liver after 24h freezing is shown in FIG. 2.
TABLE 1
(2) The hepatic artery and portal vein of the liver of each example were fixed with needles inserted, and the portal vein needles sealed for later-stage adjuvant testing. Injecting different washing liquids into hepatic portal vein according to requirement to gradually wash liver, wherein the washing process avoids bubble generation in the liver. The specific cleaning process is as follows; the livers of the respective examples were washed with pure water for 30min, red blood cells were removed, and then decellularization was performed on the respective examples under the decellularization conditions corresponding to table 1, to obtain decellularized livers of the respective examples. Among them, the decellularized livers of examples 1 to 3 and 5 are liver models thereof. The flow rates of the first and second rinsing agents were both 7mL/min (the flow rates were controlled by peristaltic pumps). The liver of example 6 after washing with purified water is shown in FIG. 3. The liver of example 6 after TritonX-100 treatment is shown in FIG. 4.
(3) The partially decellularized livers of each example were each sectioned, stained, and tested for DNA content to observe decellularization. As a result, it was found that examples 1 to 3 required a longer preparation time to achieve the same visual effect as in examples 4, 5 or 6. The results of slicing, staining and detecting the DNA content in example 6 are shown in FIGS. 8 to 11. Among them, the results of hematoxylin-eosin staining (H & E staining), immunofluorescence (Collagen I), immunofluorescence (fibrinectin), immunofluorescence (Collagen IV), and immunofluorescence (lamin) in the first row of fig. 8 are shown in the order from left to right in the first row; the second row on the scale of 100 μm in FIG. 8 is, in order from the left, a hematoxylin-eosin staining (H & E staining) result chart, an immunofluorescence (Collagen I) result chart, an immunofluorescence (fibrinectin) result chart, an immunofluorescence (Collagen IV) result chart, and an immunofluorescence (Laminin) result chart of the decellularized liver section of example 6. In FIG. 9, the first row is, from left to right, an SEM 100X scan of a normal liver, an SEM 400X scan of a normal liver and an SEM 1000X scan of a normal liver; the second row, from left to right, is the 100X scanning electron micrograph of the decellularized liver of example 6, the 400X scanning electron micrograph of the decellularized liver of example 6, and the 1000X scanning electron micrograph of the decellularized liver of example 6. FIG. 10 is a sectional microscope photograph of a decellularized liver in example 6. FIG. 11 is a graph comparing the DNA content in the decellularized liver of example 6 with a blank control.
(4) The decellularized livers of example 4 and example 6 obtained in step (2) were reinforced under the corresponding reinforcing conditions shown in table 1, to obtain liver models of example 4 and example 6. Wherein the action time of the cross-linking agent is 1 hour. The liver of example 6 treated with 0.5% SDS is shown in FIG. 5. The liver model obtained in example 1 is shown in fig. 6, and the liver models obtained in examples 4 and 5 are shown in fig. 7. In fig. 7, the liver model of example 5, the liver model of example 4, and the liver model of example 4 stored in the storage solution are shown in this order from left to right. As can be seen in fig. 6, the liver model of example 1 showed collapse and atrophy. As can be seen from fig. 7, the liver model of example 5 exhibited atrophy compared to the liver model of example 4.
(4) The liver model of example 6 was used to evaluate the embolization effect of embolization agents:
A) for the thicker vascular liver models (ex vivo liver from rabbit, pig, dog, monkey, human liver) the embolization agent was delivered into the target artery by routine TACE procedures using microcatheters, super-selective cannulation into the artery adjacent to the tumor. The embolization effect is shown in FIGS. 12-14. In FIG. 12, the liver is derived from rat, and in FIG. 12, a and b are fluorescence micrographs of rat blood vessels after FITC staining, respectively; panel c and d are fluorescence microscope images of the liquid iodized oil embolic agent treated with Nile Red; and the e picture and the f picture are respectively fluorescence microscope pictures of the PDLLA microspheres treated by the rhodamine dye. Fig. 13 is a graph showing the effect of injecting an oily dye into the liver model of example 6.
B) As shown in fig. 14, for a liver model with a thin blood vessel (for example, a liver model in which an ex vivo liver is derived from a mouse, a rat, or the like), an embolization agent is injected into the interior of a liver blood vessel directly using a long needle (22G) to embolize. The liver model in the figure is that of example 6, in which the liver is derived from rat.
The technical features of the embodiments described above may be arbitrarily combined, and for the sake of brevity, all possible combinations of the technical features in the embodiments described above are not described, but should be considered as being within the scope of the present specification as long as there is no contradiction between the combinations of the technical features.
The above-mentioned embodiments only express several embodiments of the present invention, and the description thereof is more specific and detailed, but not construed as limiting the scope of the invention. It should be noted that, for a person skilled in the art, several variations and modifications can be made without departing from the inventive concept, which falls within the scope of the present invention. Therefore, the protection scope of the present patent shall be subject to the appended claims.
Claims (11)
1. A method of preparing a liver model for testing the effect of an embolic agent, comprising the steps of:
decellularizing the isolated liver to obtain a decellularized liver; and
reinforcing the decellularized liver with a cross-linking agent to obtain the liver model; wherein:
the isolated liver is a whole organ liver, and the step of decellularizing the isolated liver comprises the following steps: washing the isolated liver with a cleaning agent, wherein the cleaning agent comprises a first cleaning agent and a second cleaning agent, and the step of washing the isolated liver with the cleaning agent comprises: irrigating the isolated liver with the first cleaning agent, wherein the first cleaning agent is TritonX-100 with the concentration of 2% -10%; and irrigating the isolated liver with the second cleaning agent, wherein the second cleaning agent is 0.5-10% of sodium dodecyl sulfate;
said step of reinforcing said decellularized liver with a cross-linking agent comprises: perfusing the cross-linking agent into the decellularized liver to consolidate the decellularized liver.
2. The method for preparing a liver model according to claim 1, wherein the first cleaning agent is Triton X-100 with a concentration of 4% to 10%; the second cleaning agent is 1% -10% of sodium dodecyl sulfate.
3. The method for preparing a liver model according to claim 1, wherein the cleaning time of the first cleaning agent is 0.1 to 100 hours; the cleaning time of the second cleaning agent is 0.1-100 hours.
4. The method for preparing a liver model according to claim 3, wherein the flow rate of the first cleaning agent is 0.1-100 mL/min; the flow rate of flushing by the second cleaning agent is 0.1-100 mL/min.
5. The method for preparing a liver model according to claim 1, wherein the crosslinking agent comprises an imide ester crosslinking agent, an N-hydroxysuccinimide ester crosslinking agent, a maleimide crosslinking agent, a haloacetyl crosslinking agent, a dithiodipyridine crosslinking agent, a hydrazide crosslinking agent, a carbodiimide crosslinking agent, an organic peroxide crosslinking agent, a silane crosslinking agent, an azide crosslinking agent, a divinyl sulfone crosslinking agent, a 1, 4-butanediol diglycidyl ether crosslinking agent, a crosslinking agent containing two or more unsaturated bonds, an amine, an oxime, an organic sulfide, a phenol resin, an organic dibasic acid, a polyhydric alcohol, glutaraldehyde, formaldehyde, acetic anhydride, diglycidyl ether, methyl suberate, carbodiimide, oxidized sodium alginate, gelatin, chitosan, aziridine, an amino resin, At least one of genipin and ammonium peroxysulfate inorganic cross-linking agent.
6. The method for preparing a liver model according to claim 5, wherein the crosslinking agent is a mixture of N-hydroxysuccinimide and 1-ethyl- (3-dimethylaminopropyl) -3-ethylcarbodiimide hydrochloride, and the molar concentration ratio of N-hydroxysuccinimide to 1-ethyl- (3-dimethylaminopropyl) -3-ethylcarbodiimide hydrochloride is 1:4 to 10.
7. The method for preparing a liver model according to claim 6, wherein the first cleaning agent is TritonX-100 with a concentration of 4%, the second cleaning agent is sodium dodecyl sulfate with a concentration of 0.5%, and the cleaning time of the first cleaning agent is 2 hours; the cleaning time of the second cleaning agent is 3 hours; the flow rate of flushing by the first cleaning agent is 7 mL/min; the flow rate of the second cleaning agent flushing is 7 mL/min.
8. The method for preparing a liver model according to claim 6, wherein the flow rate of the cross-linking agent added to the decellularized liver in the step of perfusing the cross-linking agent into the decellularized liver to consolidate the decellularized liver is 1mL/min to 20 mL/min.
9. The method of preparing a liver model according to any one of claims 1 to 8, further comprising a step of freezing the ex vivo liver prior to the step of decellularising the ex vivo liver.
10. A liver model produced by the method for producing a liver model according to any one of claims 1 to 9.
11. Use of the liver model of claim 10 for testing the effect of an embolic agent.
Priority Applications (1)
| Application Number | Priority Date | Filing Date | Title |
|---|---|---|---|
| CN201910042221.8ACN109671346B (en) | 2019-01-17 | 2019-01-17 | Liver model and preparation method and application thereof |
Applications Claiming Priority (1)
| Application Number | Priority Date | Filing Date | Title |
|---|---|---|---|
| CN201910042221.8ACN109671346B (en) | 2019-01-17 | 2019-01-17 | Liver model and preparation method and application thereof |
Publications (2)
| Publication Number | Publication Date |
|---|---|
| CN109671346A CN109671346A (en) | 2019-04-23 |
| CN109671346Btrue CN109671346B (en) | 2021-11-19 |
Family
ID=66149457
Family Applications (1)
| Application Number | Title | Priority Date | Filing Date |
|---|---|---|---|
| CN201910042221.8AActiveCN109671346B (en) | 2019-01-17 | 2019-01-17 | Liver model and preparation method and application thereof |
Country Status (1)
| Country | Link |
|---|---|
| CN (1) | CN109671346B (en) |
Families Citing this family (1)
| Publication number | Priority date | Publication date | Assignee | Title |
|---|---|---|---|---|
| CN112116860B (en)* | 2020-10-23 | 2022-06-10 | 北京博医时代教育科技有限公司 | Model for upper abdomen operation training and manufacturing method thereof |
Family Cites Families (4)
| Publication number | Priority date | Publication date | Assignee | Title |
|---|---|---|---|---|
| KR20190112868A (en)* | 2006-10-06 | 2019-10-07 | 안트로제네시스 코포레이션 | Native(telopeptide) Placental Collagen Compositions |
| WO2014172618A2 (en)* | 2013-04-19 | 2014-10-23 | The Board Of Trustees Of The University Of Illinois | Compositions and method for treating thrombosis |
| RU2621419C1 (en)* | 2016-08-30 | 2017-06-06 | Георгий Александрович Полев | Method for visualization of arterial and venous vessels of human skull base and brain for their topographic and anatomical examination |
| CN107988158B (en)* | 2017-11-27 | 2020-11-13 | 大连理工大学 | A three-dimensional tumor model decellularized porous scaffold, construction method and application thereof |
- 2019
- 2019-01-17CNCN201910042221.8Apatent/CN109671346B/enactiveActive
Non-Patent Citations (2)
| Title |
|---|
| Decellularized liver as a practical scaffold with a;N. Shirakigawa, H. Ijima, T. Takei;《Journal of Bioscience and Bioengineering》;20120619;第546-551页* |
| Light activated cell migration in synthetic extracellular matrices;Qiongyu Guo,Xiaobo Wang,Mark W.Tibbitt,Kristi S.Anseth;《Biomaterials》;20120811;第8040-8046页* |
Also Published As
| Publication number | Publication date |
|---|---|
| CN109671346A (en) | 2019-04-23 |
Similar Documents
| Publication | Publication Date | Title |
|---|---|---|
| US20220062349A1 (en) | Decellularization and recellularization of organs and tissues | |
| Zambon et al. | Comparative analysis of two porcine kidney decellularization methods for maintenance of functional vascular architectures | |
| Verstegen et al. | Decellularization of whole human liver grafts using controlled perfusion for transplantable organ bioscaffolds | |
| Ko et al. | Bioengineered transplantable porcine livers with re-endothelialized vasculature | |
| Gerli et al. | Perfusion decellularization of a human limb: A novel platform for composite tissue engineering and reconstructive surgery | |
| CN112546302B (en) | Human liver scaffold | |
| Gessner et al. | Functional ultrasound imaging for assessment of extracellular matrix scaffolds used for liver organoid formation | |
| Yap et al. | The vascularised chamber as an in vivo bioreactor | |
| Ko et al. | Enhanced re-endothelialization of acellular kidney scaffolds for whole organ engineering via antibody conjugation of vasculatures | |
| JPWO2017175870A1 (en) | Transplant for liver tissue reconstruction that has undergone hepatectomy, its production method, and method for reconstruction of liver that has undergone liver resection | |
| Singh et al. | Point-of-care treatment of geometrically complex midfacial critical-sized bone defects with 3D-Printed scaffolds and autologous stromal vascular fraction | |
| Tran et al. | The use of gadolinium-carbon nanostructures to magnetically enhance stem cell retention for cellular cardiomyoplasty | |
| US20190125930A1 (en) | Bioscaffold, method for producing the same, and uses thereof | |
| CN109671346B (en) | Liver model and preparation method and application thereof | |
| Vasanthan et al. | Extracellular matrix extraction techniques and applications in biomedical engineering | |
| US20170049941A1 (en) | Method of Preparing Artificial Organs, and Related Compositions | |
| Wang et al. | A survival model of in vivo partial liver lobe decellularization towards in vivo liver engineering | |
| Amoroso et al. | Functional and morphological studies of in vivo vascularization of 3D-bioprinted human fat grafts | |
| Redenski et al. | Microcomputed tomography-based analysis of neovascularization within bioengineered vascularized tissues | |
| Alves et al. | Current considerations in medical device pathology | |
| CN111544658B (en) | Cardiovascular implant for regulating and controlling immune response and promoting intimal regeneration and preparation method thereof | |
| Li et al. | Preparation and mechanical behavior of the acellular porcine common bile duct and its immunogenicity in vivo | |
| Fu et al. | Noninvasive Monitoring of Allogeneic Stem Cell Delivery with Dual‐Modality Imaging‐Visible Microcapsules in a Rabbit Model of Peripheral Arterial Disease | |
| Macchiarelli et al. | Scanning electron microscopy of blood vascular corrosion casts in mammals | |
| Al-Abboodi | Application of the rat arteriovenous loop model for lymphangiogenesis and for the generation of tumor tissue |
Legal Events
| Date | Code | Title | Description |
|---|---|---|---|
| PB01 | Publication | ||
| PB01 | Publication | ||
| SE01 | Entry into force of request for substantive examination | ||
| SE01 | Entry into force of request for substantive examination | ||
| GR01 | Patent grant | ||
| GR01 | Patent grant |